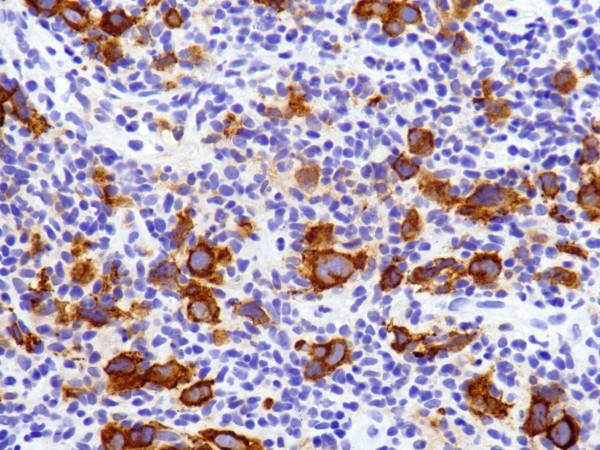
cd30 经典型霍奇金淋巴瘤rs细胞阳性表达

rs细胞

箭头所示rs细胞,细胞体积大,核仁明显,是霍奇金淋巴瘤特征性reed
图片尺寸504x331
看图识细胞第63期
图片尺寸750x750
经典霍奇金淋巴瘤chl新药默沙东keytruda在欧盟获批疗效
图片尺寸422x320
cd30 经典型霍奇金淋巴瘤rs细胞阳性表达
图片尺寸600x450
此图显示rs细胞内 pdl1和 pdl2基因位点以及pd-l1和pd-l2蛋白
图片尺寸1200x2590
电子显微镜下的乳腺癌细胞,后期上色(图:wellcomecollection)▼现在
图片尺寸660x880
电子显微镜下的乳腺癌细胞,后期上色(图:wellcomecollection)▼现在
图片尺寸660x880
网易首页>网易号>正文申请入驻> 原始粒细胞产板巨核分叶过多,似"鹿角
图片尺寸660x452
西安工程大学清华大学advancedmaterials
图片尺寸1080x885
r-s细胞
图片尺寸200x134
红细胞形态大致正常.血小板增多.血片:血常规:提示
图片尺寸660x665
网易首页>网易号>正文申请入驻> 类p-h畸形原始粒细胞及颗粒减少的晚
图片尺寸660x527
网易首页>网易号>正文申请入驻> 原始粒细胞及颗粒减少的晚幼粒细胞
图片尺寸660x604
英敏特热门原料五味子的提取功能及应用研究
图片尺寸554x441
红细胞形态大致正常.血小板增多.血片:血常规:提示贫血,血小板增多.
图片尺寸660x502
血脂血糖,葡聚糖试验,pct,g6pd基因检测,coobms试验,红白细胞cd55
图片尺寸660x486
获奖名单答案丽拓杯君安医学细胞形态学大赛
图片尺寸636x587
可见大的非典型细胞类似于rs样细胞,背景为组织细胞和小淋巴细胞(图a
图片尺寸789x1000
rs细胞名词解释?
图片尺寸600x400
粒系病态(造血)细胞形态学
图片尺寸603x456